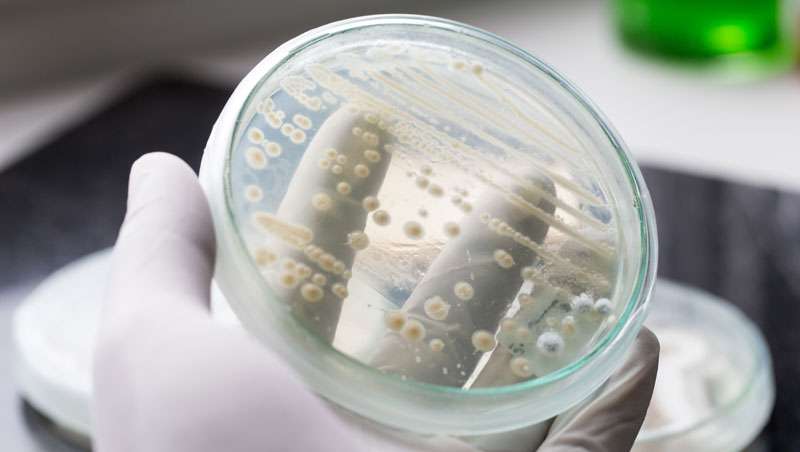

Micoterapia, hongos medicinales que previenen enfermedades
La Clínica Omega Zeta presenta sus tratamientos de micoterapia, basados en el uso de las setas, que previenen y tratan enfermedades, caso de procesos oncológicos con hongos o autoinmunes, entre otras, con hongos medicinales
-
Collagen Fast Track: belleza que se siente, movimiento que se vive
El colágeno inteligente que cuida piel, cabello, uñas y articulaciones desde dentro
-
Skin Burn-out, el agotamiento cutáneo que llega con el frío y cómo frenarlo antes de que tu piel colapse
Ni seca, ni sensible: tu piel está agotada. Descubre cómo este escudo probiótico de Farma Dorsch reinicia tu piel
-
Febrero es autoamor: Eiralabs invita a convertir el cuidado propio en un ritual diario
En febrero, Eiralabs invita a convertir el autocuidado en un gesto cotidiano de amor propio, proponiendo pequeños rituales que unen bienestar, constancia y placer consciente para transformar la rutina en momentos de calma y equilibrio
-
Nuxe lanza Nuxuriance Ultra Alfa [3R]: la nueva crema antimanchas y antiedad SPF30
Una innovación con doble acción experta antimanchas y antiedad: previene, corrige y protege
-
Infarma Madrid 2026, cita clave de la farmacia europea
Ifema Madrid acogerá del 24 al 26 de marzo el mayor encuentro profesional de la oficina de farmacia en Europa
-
La Directora de I+D de Anian: el cuidado del cuero cabelludo es la nueva gran tendencia de belleza
Anian revela por qué el scalp care es clave
La Clínica Omega Zeta, especializada en medicina integrativa, presenta sus tratamientos de micoterapia, una terapia natural que, a través del uso de hongos medicinales, permite tratar y prevenir enfermedades de forma efectiva y no invasiva.
La Dra. Asunción Peiré, subdirectora médica de la Clínica Omega Zeta y especialista en medicina integrativa, farmacología pediátrica y micoterapia apunta que “el uso de las setas en medicina puede llevarse a cabo con fines preventivos, pues son suplementos nutricionales, o como tratamiento complementario, no sustitutivo, en enfermedades autoinmunes, en procesos infecciosos, asmáticos y alérgicos, neuropatías, trastornos psicológicos, e incluso en oncología”.
Una terapia con muchos recursos
Es la propia Peiré quien nos enumera algunas de las enfermedades o dolencias que pueden ser tratadas con la micoterapia: infecciones bacterianas o víricas, como los herpes y el Virus del Papiloma Humano; infecciones bucales; enfermedades autoinmunes, como tiroides, colitis, psoriasis; enfermedades alérgicas; patologías cardiovasculares, como diabetes, colesterol o hipertensión; enfermedades neurodegenerativas, como Alzheimer y Parkison, así como también diferentes síndromes.
En oncología, "aparte de la prevención, que es efectiva, hay aplicaciones para cada tipo de cáncer porque los hongos medicinales son capaces de interactuar con el sistema inmunitario", asegura la doctora Asunción Peiré.
En cuanto a sus más importantes cualidades y propiedades, destacar que “la principal propiedad terapéutica de los hongos es que son inmunomoduladores, de tal manera que cuando hay un desequilibro en el sistema inmunitario no lo estimulan ni lo inhiben, sino que corrigen el desequilibrio”. Y añade: “Si hay un exceso de inmunidad en una enfermedad autoinmune, en una alergia, asma, lo que harán es rebajar el nivel para que el sistema inmunitario funcione mejor. Pero si, al contrario, tenemos un déficit, lo que hacen es aumentar las defensas naturales del cuerpo. Por tanto, se dice que actúan allí donde hace falta”.
Sin contraindicaciones, la micoterapia está indicada para todos. Los únicos efectos secundarios se darían en las personas alérgicas a las setas y las que estén tomando medicamentos anticoagulantes. Al principio del tratamiento, los pacientes pueden experimentar malestares digestivos, pero esto solo suele durar dos o tres días, como parte del proceso de desintoxicación del organismo.

Cada hongo para un fin concreto
En la Clínica Omega Zeta se utilizan diferentes tipos de hongos para tratar distintas dolencias, por ejemplo:
- Reishi, para equilibrar mentalmente, prevenir cáncer, como regulador hormonal y para mejorar el sistema inmunitario.
- Shitake para estimular el sistema inmunitario en caso de alergias.
- Hongo de la energía, para los deportistas.
- Polyporus Umbellatus, que es un diurético, drenante linfático y mucolítico pulmonar.
- Cordiceps, utilizado en casos de depresión, cáncer y para corregir la fibrosis del hígado.
- Faricomus omeratus, un antiviral por excelencia que previene y cura e incluso si hay lesiones precancerígenas es capaz de revertirlas.
- Maitake, utilizado para la diabetes, tanto la tipo uno como la dos.
- Seta Barbuda, que es un regulador de la tensión y los niveles de glucosa.
La Unidad de Micoterapia de la Clínica Omega Zeta aprovecha el potencial de los extractos de diversos hongos medicinales para la prevención y tratamiento integrativo de diferentes patologías.

Recomendamos














